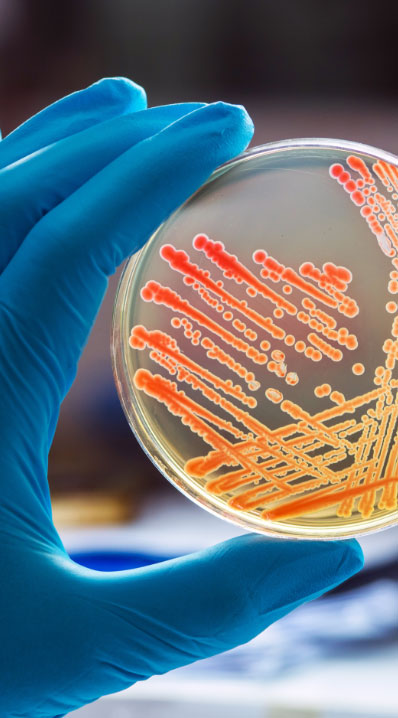

Give us a call
Our Promise

You put faith in where your family’s food comes from. When that trust is violated, you and your family are left to suffer.
OFT Food Safety & Injury Lawyers was built to get the answers you need. We also get you the results you deserve. We have recovered millions for our clients.
Our food poisoning lawyers are renowned within the food safety industry. We have the food poisoning litigation experience to get results fast. We handle food injury cases nationwide and are ready to put our knowledge, experience, and resources behind your case.
Contact us for a free, no-obligation consultation.



Our Attorneys
I have been a foodborne illness attorney my entire career. There may not be another attorney in America that can say that. It is all I’ve ever done. It is all I know. I know it well.
I am passionate about food safety. If your foodborne illness can possibly be linked to a source, I will find it. I take pride in leaving no stone unturned. I pursue every legal avenue possible to get you justice.
The most rewarding part of my job is connecting with my clients. When you hire OFT we will be working together to get the best possible outcome. Every case is personal to me. You will be able to contact me at all hours of the day via email, text, or phone with any questions or concerns you have. We work for you. Never forget that.

I put my clients first by listening and learning about their lives. I commit to the client’s case and build trust. For me, this trust is the bedrock for effective communication and representation.
When a person trusts me at a time when they are at their most vulnerable – physically, financially, and emotionally. They deserve absolute honesty from their lawyer. I am committed to complete honesty with my clients.
Great lawyers have a passion for their client’s cause that goes beyond mere work. To reach that level, we must forge meaningful relationships with our clients and their families. It takes commitment, time, and heart. The result is a passion in advocacy that will resonate with juries and judges. Insurance companies and large corporations fight with teams of lawyers and well-paid experts. Yet they can never match the passion of a great trial attorney.

I have worked for a big corporate-focused firm and represented all sorts of companies in all sorts of litigation. What truly drives me, however, is working for regular people. I relish the chance to go toe-to-toe with big corporations and high-priced lawyers. What I’ve learned is the quality of legal work is not driven by pedigree, but rather passion for a cause.
At OFT, I use my diverse legal background to help analyze complex legal and scientific issues. I take pride in offering careful strategic counsel to my clients. I will gladly fight for what is right for my clients.

Eleanor grew up on a small farm in central Minnesota and knows that keeping our food safe starts at the farm. Her mother and father have been farming for nearly forty years, and her older brother recently joined the family business raising beef cattle and sheep. Eleanor knows her work at OFT helps shape a food system that elevates food producers, like her parents and brother, who prioritize the quality and safety of their food products over their bottom lines.

Our Practice Areas
Thousands of those who become ill require hospitalization. There are roughly 3,000 fatalities annually due to unsafe food.
A pathogen is a bacterial, viral, or other infectious agent that causes disease. When a pathogen, toxic substance, or unsafe practice encounters your food supply, it can wreak havoc on your system, causing incredible illness.
The sources of foodborne illnesses can vary. From manufacturers, growers, retail stores, distributors, and processing facilities to improper temperature controls, cook times, and unsanitary conditions, when food safety procedures fail or are ignored in favor of profits, customers like you are put at risk.
At OFT Food Safety & Injury Lawyers, we can help you recover damages if you or a loved are suffering from any of the following:
Because of our reputation for excellence and experience with complex cases, we also have experience handling:
Food Poisoning Law and the Role of an Attorney

From our first conversation, we will answer your questions about the legal process and the steps necessary to file a food poisoning lawsuit. We closely monitor food poisoning outbreaks and can often provide critical information about the source of your illness.
If you have already received a diagnosis and know the source of your illness, we are also ready to act fast and pursue full and fair compensation for your losses, including:
In general, food poisoning lawsuits are similar to other product liability claims where a manufacturer is responsible for putting a defective product in the hands of a customer. We must prove the product was dangerous when used as intended.
Food poisoning cases, however, are uniquely complex. In contrast to a typical product liability case where the product itself can be analyzed, the illness-causing food has been consumed and is therefore unavailable for testing. In addition, the incubation period — the time between consumption and first symptom — for most pathogens is at least 24 to 48 hours and can be more than a month, making it even more difficult to identify the source of an illness. Modern food production also usually involves multiple parties and an array of overlapping rules and regulations.
An attorney experienced in food poisoning cases can identify the critical information quickly, trace the contaminated food through the chain of distribution, assemble medical and public health experts to prove the case, and get results.
Yes. Every state has a different “statute of limitations," that outlines the timeframe to file a personal injury claim. Waiting too long may result in losing the right to bring a case. That’s why it is always best to speak to a food poisoning lawyer sooner rather than later.
Too many foodborne illnesses go unreported, which is a crucial step in making food safer. By reporting a foodborne illness, agencies and health departments become aware of potential outbreaks. This can lead to faster recalls and potentially fewer victims. To report a suspected foodborne illness, you can contact the health department on your own or talk to a doctor. We usually recommend speaking to a medical professional, who can diagnose your condition through a stool or other test. If you test positive for a foodborne illness, the doctor or lab will automatically report your case to the appropriate agency. We can also help you find out where to report your illness.
This largely depends on the circumstances or pathogen involved, but food poisoning is often diagnosed as “gastroenteritis.” This is a general term describing intestinal dysfunction marked by diarrhea, abdominal cramps, nausea or vomiting, and sometimes fever. This type of diagnosis does not identify the cause or specific pathogen causing the infection. Usually, doctors will order additional tests, including blood work and a stool culture for more definitive information. In some cases, a spinal fluid test may be necessary. Obtaining a precise diagnosis through a culture is a critical part of proving a food poisoning case. Please contact us for additional information.
Virtually any food product can cause illness. In recent years, fresh produce and fruit have been associated with some of the largest outbreaks. Other common causes of food poisoning are raw or undercooked meat and poultry, unpasteurized dairy products, unwashed produce, and food that has been improperly refrigerated.
Cross-contamination is the transfer of harmful bacteria from raw food to other ready-to-eat foods or to cutting boards, utensils, food handlers, or other surfaces. Cross-contamination is a very common root cause of food poisoning outbreaks.
There is no easy answer to this question, and it depends on several factors. It’s best to contact an experienced food poisoning lawyer to talk through the facts of your specific case. They will be better able to answer your questions, direct your next steps, identify who is responsible, and honestly assess your case.
Trust Us to Set Things Right

With decades of experience in the food safety field and millions of dollars recovered in food poisoning settlements and verdicts, OFT Food Safety & Injury Lawyers have the skill and resources to handle any food poisoning case. We are passionate about safe food and client service.
Our commitment to you:
Foodborne illness cases are different. Whether you contracted E. coli from produce, Listeria from cheese, or Salmonella from a restaurant, you will need attorneys with experience, technical know-how, and proven results.
Some typical symptoms associated with food poisoning are:
If you believe you or a loved one have contracted a foodborne illness or have food poisoning symptoms, you should take action:
Get medical treatment immediately.
Request that your doctor order a stool culture to identify the specific pathogen that caused your illness.
Notify your state or local health department.
Contact an experienced foodborne illness lawyer. We offer free consultations and are happy to answer any questions you have.